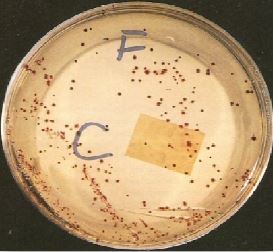

النبات

مواضيع عامة في علم النبات

الجذور - السيقان - الأوراق

النباتات الوعائية واللاوعائية

البذور (مغطاة البذور - عاريات البذور)

الطحالب

النباتات الطبية


الحيوان

مواضيع عامة في علم الحيوان

علم التشريح

التنوع الإحيائي

البايلوجيا الخلوية


الأحياء المجهرية

البكتيريا

الفطريات

الطفيليات

الفايروسات


علم الأمراض

الاورام

الامراض الوراثية

الامراض المناعية

الامراض المدارية

اضطرابات الدورة الدموية

مواضيع عامة في علم الامراض

الحشرات


التقانة الإحيائية

مواضيع عامة في التقانة الإحيائية


التقنية الحيوية المكروبية

التقنية الحيوية والميكروبات

الفعاليات الحيوية

وراثة الاحياء المجهرية

تصنيف الاحياء المجهرية

الاحياء المجهرية في الطبيعة

أيض الاجهاد

التقنية الحيوية والبيئة

التقنية الحيوية والطب

التقنية الحيوية والزراعة

التقنية الحيوية والصناعة

التقنية الحيوية والطاقة

البحار والطحالب الصغيرة

عزل البروتين

هندسة الجينات


التقنية الحياتية النانوية

مفاهيم التقنية الحيوية النانوية

التراكيب النانوية والمجاهر المستخدمة في رؤيتها

تصنيع وتخليق المواد النانوية

تطبيقات التقنية النانوية والحيوية النانوية

الرقائق والمتحسسات الحيوية

المصفوفات المجهرية وحاسوب الدنا

اللقاحات

البيئة والتلوث


علم الأجنة

اعضاء التكاثر وتشكل الاعراس

الاخصاب

التشطر

العصيبة وتشكل الجسيدات

تشكل اللواحق الجنينية

تكون المعيدة وظهور الطبقات الجنينية

مقدمة لعلم الاجنة


الأحياء الجزيئي

مواضيع عامة في الاحياء الجزيئي


علم وظائف الأعضاء


الغدد

مواضيع عامة في الغدد

الغدد الصم و هرموناتها

الجسم تحت السريري

الغدة النخامية

الغدة الكظرية

الغدة التناسلية

الغدة الدرقية والجار الدرقية

الغدة البنكرياسية

الغدة الصنوبرية

مواضيع عامة في علم وظائف الاعضاء

الخلية الحيوانية

الجهاز العصبي

أعضاء الحس

الجهاز العضلي

السوائل الجسمية

الجهاز الدوري والليمف

الجهاز التنفسي

الجهاز الهضمي

الجهاز البولي


المضادات الميكروبية

مواضيع عامة في المضادات الميكروبية

مضادات البكتيريا

مضادات الفطريات

مضادات الطفيليات

مضادات الفايروسات

علم الخلية

الوراثة

الأحياء العامة

المناعة

التحليلات المرضية

الكيمياء الحيوية

مواضيع متنوعة أخرى

الانزيمات
الحالات المرضية البكتيرية : الحالة التاسعة والعشرون
المؤلف:
عبد الرزاق سليمان التومي ، محمد محمد الامام ، عبد الباسط رمضان
المصدر:
اساسيات التشخيص البكتريولوجي المعملي والسريري
الجزء والصفحة:
4-9-2016
2089
الحالات المرضية البكتيرية : الحالة التاسعة والعشرون
مريض يبلع من العمر خسة عشر سنة تم إيوائه المستشفى وهو يعاني من آلام في الربع السفلي من البطن وحمى تم تشخيص الحالة على أنها التهاب الزائدة الدودية Appenditis ،وعند إجراء العملية تبين عدم صحة هذا التشخيص ولوحظ تضخم العقد اليمفاوية mesenteric وبالتقصي تبين أن الأخ الأصغر الذي يبلغ من العمر اربع سنوات كان مصاباً بإسهال وحمى مع آلام في البطن وشفي تلقائياً كما ان والده يشتكي من منزلة معوية مصحوبة بانتفاخ القدم والركبة مع ظهور عقد مؤلمة في مقدمة الساق. عند تنمية عينة من العقد الليمفاوية mesenteric وعينة من براز المريض الذي تم إيوائه المستشفى على الوسط الغذائي الانتقائي cefsulodin – Igrasan – novobiocin medium اظهرت النتيجة مستعمرات بكتيرية غير مخمرة لسكر اللاكتوز وهي سالبة لصبغة جرام.
الشكل رقم 1 : المزرعة البكتيرية
الأسئلة :
1- ما تعريفك الافتراضي للكائن الدقيق المعزول ؟
2- هل هناك علاقة بين إصابة الأب وأبنائه ؟
3- ما هو العلاج الذي تقترحه لعلاج هذه الحالة ؟
الإجابة :
1- من الشكل رقم 1.29 فإن الكائن الدقيق المعزول من المحتمل ان يعرف بأنه الجنس البكتيري Yersinia Spp أما النوع البكتيري enterocolitica او pseudotuberculosis والتشخيص السرسري قد يدل على الإصابة بمرض الـ yersiniosis.
2- نعم هناك علاقة بين إصابة الأب وأبنائه حيث أن أعراض الإصابة بهذا المرض تختلف من شخص لآخر حسب الفئة العمرية للمرضى كما هو ملاحظ في هذه الحالة .
غالباً ما يتم عزل النوع البكتيري Y. enterocoliticia من عينة البراز وقد يتم عزل هذه البكتيريا من عينة العقد الليمفاوية والتشخيص الأمثل لهذا المرض يتم باستعمال الطرق المصلية مع العلم أنه في الحالات المزمنة فإن نتيجة عينة البراز وعينة المصل تكون سالبة وفي هذه الحالة يتم تحديد وجود هذه البكتيريا باستعمال تقنية immunoblotting للكشف عن بروتين الغشاء الخارجي لهذه البكتيريا .
3- غالباً ما تختفي أعراض النزلة المعوية مع مرور الوقت وليس هناك داعي لاستعمال المضادات الحيوية اما عند ظهور المرض بحيث تصاب بعض اجهزة الجسم فيتم استعمال المضاد الحيوي doxycycline او المضاد الحيوي co– trimoxazole .
 الاكثر قراءة في البكتيريا
الاكثر قراءة في البكتيريا
 اخر الاخبار
اخر الاخبار
اخبار العتبة العباسية المقدسة

الآخبار الصحية















 قسم الشؤون الفكرية يصدر كتاباً يوثق تاريخ السدانة في العتبة العباسية المقدسة
قسم الشؤون الفكرية يصدر كتاباً يوثق تاريخ السدانة في العتبة العباسية المقدسة "المهمة".. إصدار قصصي يوثّق القصص الفائزة في مسابقة فتوى الدفاع المقدسة للقصة القصيرة
"المهمة".. إصدار قصصي يوثّق القصص الفائزة في مسابقة فتوى الدفاع المقدسة للقصة القصيرة (نوافذ).. إصدار أدبي يوثق القصص الفائزة في مسابقة الإمام العسكري (عليه السلام)
(نوافذ).. إصدار أدبي يوثق القصص الفائزة في مسابقة الإمام العسكري (عليه السلام)


















